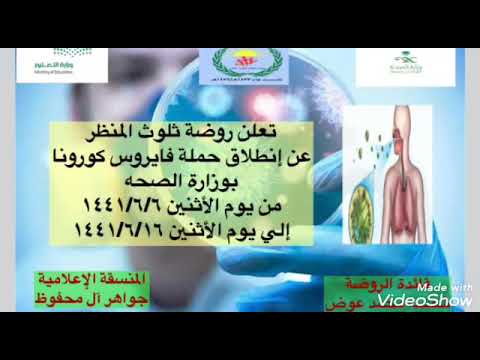
الحملة الاعلامية للتوعية بفيروس كورونا بمدارس مكتب تعليم بارق

بارق فيروس
-

-

فايروس قريبا بارق الحياني اكسبلور المراره لايك تصميم فيديوهات تصويري دويتو
مدة الفيديو: 0:44
تحميل »
فايروس قريبا بارق الحياني اكسبلور المراره لايك تصميم فيديوهات تصويري دويتو
-

-

-

قريبا اا ڤايروس في كل العراق أنتضروناا بارق اكسبلور ترند العراق تيك توك انستقرام
مدة الفيديو: 2:22
تحميل »
قريبا اا ڤايروس في كل العراق أنتضروناا بارق اكسبلور ترند العراق تيك توك انستقرام
-

-

-

اعلان لفيلم فايروس ابو جنه مع بارقأبد ما چنة منتظرين غير الطيور بارق مسلم اكسبلور ال
مدة الفيديو: 1:12
تحميل »
اعلان لفيلم فايروس ابو جنه مع بارقأبد ما چنة منتظرين غير الطيور بارق مسلم اكسبلور ال
-

-
الحملة الاعلامية للتوعية بفيروس كورونا بمدارس مكتب تعليم بارق
مدة الفيديو: 1:16
تحميل »
الحملة الاعلامية للتوعية بفيروس كورونا بمدارس مكتب تعليم بارق
-

-

فلم بارق جديد العلم اكسبلور اكسبلور ماوراءيات ماوراءيات معلومات معلومات اهميه اهميه
مدة الفيديو: 0:25
تحميل »
فلم بارق جديد العلم اكسبلور اكسبلور ماوراءيات ماوراءيات معلومات معلومات اهميه اهميه
-

بارق اجه بلوقت الصح وجاب ام لعيد بارق جوليان نارو لايك واشتراك بلقناة تيسير العراقيه
مدة الفيديو: 0:38
تحميل »
بارق اجه بلوقت الصح وجاب ام لعيد بارق جوليان نارو لايك واشتراك بلقناة تيسير العراقيه
-

بارق و ياني و داني فول ياني وداني بارق
مدة الفيديو: 0:05
تحميل »
بارق و ياني و داني فول ياني وداني بارق
-

-

قصة بارق مع زوج الجنية حسيون شاهد للأخير
مدة الفيديو: 28:39
تحميل »
قصة بارق مع زوج الجنية حسيون شاهد للأخير